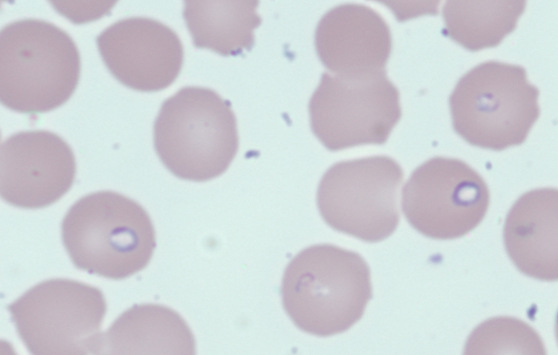

Case of Anemia and Thrombocytopenia



There are some conditions missing from the list of extracorpuscular hemolysis. What are they?
Click for AnswerWe will come to the peripheral smear shortly, but which of the following labs would be most helpful (choose the one most appropriate answer):
The reticulocyte count was elevated (140 x 109/L). This is an appropriate response to anemia and suggests that the patient has hyperproliferative anemia.
Here are the results of the tests you considered in the last question:

True or false: these results are consistent with hemolysis.
Here are the results of the tests you considered in the last question:

So having “reverse engineered” the case, we are now ready for a history!
60 yo F with asplenia (past gastrectomy/splenectomy for gastric spindle cell tumor) presented to ED with:

The patient had a diagnosis of babesiosis with 10.3% parasitemia on her thin smear. She was treated with atovaquone and azithromycin x 6 weeks. Because of her history of splenectomy and the high % parasitemia, she received red cell exchange x 6 rounds. The level of parasitemia on thin smears trended down and eventually became negative 9 days after admission.